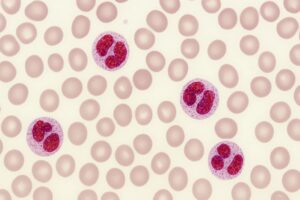

Publikacje







Czy moje dziecko rośnie prawidłowo?
Czy moje dziecko rośnie prawidłowo? Siatki centylowe, tempo wzrastania i […]



Niewydolność serca w codziennym życiu – objawy, które pacjenci mylą ze zmęczeniem lub wiekiem
Najbardziej podstępne choroby nie wchodzą z hukiem. Wchodzą po cichu, […]

Polipy nosa – leczenie biologiczne jako nowoczesna szansa dla pacjentów

Zapalenie zatok – jak rozpoznać, leczyć i unikać powikłań?
Zapalenie zatok to problem, który dotyka milionów ludzi na całym […]


Rehabilitacja zaburzeń głosu – Droga do zdrowia twojego głosu
Zaburzenia głosu mogą dotknąć każdego, niezależnie od wieku czy stylu […]

Przewlekłe zapalenie zatok przynosowych z polipami nosa (PZZPzPN) – wyzwanie dla pacjentów i systemu ochrony zdrowia
Przewlekłe zapalenie zatok przynosowych z polipami nosa (PZZPzPN) to schorzenie, […]


Zachowania szkodliwe dla uszu – pora z nich zrezygnować
Niektóre z naszych codziennych zwyczajów mogą niekorzystnie wpłynąć na zdrowie […]

Ostre zapalenie ucha środkowego u maluchów: Jak je rozpoznać i efektywnie leczyć?
Otolaryngologia dla rodzicówNiepokój rodziców wobec ostrego zapalenia ucha środkowego (OZUŚ) […]

Przewlekły kaszel okiem laryngologa
Kaszel (łac. tussis; ang. cough) to najczęstszy objaw chorób dróg […]

Zapalenia migdałków. Przerost migdałka gardłowego.
Magdalena ArcimowiczSpecjalista otolaryngolog – alergologMigdałki, czyli skupiska tkanki chłonnej, odgrywają […]

Nawracające infekcje
Dr n. med. Magdalena ArcimowiczSpecjalista otolaryngolog – alergolog Dzieci, zwłaszcza […]

Zapalenie ucha u dziecka
Magdalena ArcimowiczSpecjalista otolaryngolog-alergologZapalenie ucha u dzieckaStany zapalne uszu u dzieci, […]

Jak wzmocnić odporność?
Magdalena ArcimowiczSpecjalista otolaryngolog – alergologOdporność to zestaw różnorodnych mechanizmów, w […]

IMMUNOTERAPIA SWOISTA (SIT) – odczulanie
IMMUNOTERAPIA SWOISTA (SIT) – odczulanie to metoda leczenia polegająca na podawaniu w […]

Skrzywienie przegrody nosa, możliwości leczenia operacyjnego
Autorzy: Dr n. med. Magdalena Arcimowicz, Dr n. med. Arkadiusz PaprockiSkrzywienie […]

Chrapanie i obturacyjny bezdech podczas snu
Autor: dr med. Jarosław BalcerzakChrapanie jest zjawiskiem spotykanym tak często, że większość […]

WIOSNA, ALERGIA I KORONAWIRUS – czyli jak przeżyć kolejny sezon pylenia w czasach pandemii
Autor:Dr n. med. Magdalena ArcimowiczSpecjalista otolaryngolog – alergolog Pandemia koronawirusa rozwinęła […]

Alergie – czy warto się odczulać
Dr n. med. Magdalena ArcimowiczKatedra i Klinika Otolaryngologii Warszawskiego Uniwersytetu […]

Stanowisko grupy ekspertów Polskiego Towarzystwa Alergologicznego w sprawie postępowania u chorych na astmę i choroby alergiczne w okresie pandemii SARS-CoV-2
Marek L Kowalski1, Zbigniew Bartuzi2, Anna Bręborowicz3, Magdalena Czarnecka-Operacz4, Jerzy […]

Zawroty głowy
Dr n. med. Arkadiusz PaprockiKatedra i Klinika Otolaryngologii Warszawskiego Uniwersytetu MedycznegoMokotowskie […]

Dermatologia
Dermatologia to dziedzina zajmująca się diagnostyką i leczeniem chorób skóry, włosów […]

Dermatologia dziecięca
Dermatologia dziecięca to bardzo ciekawa, a jednocześnie chyba najtrudniejsza dziedzina dermatologii. […]